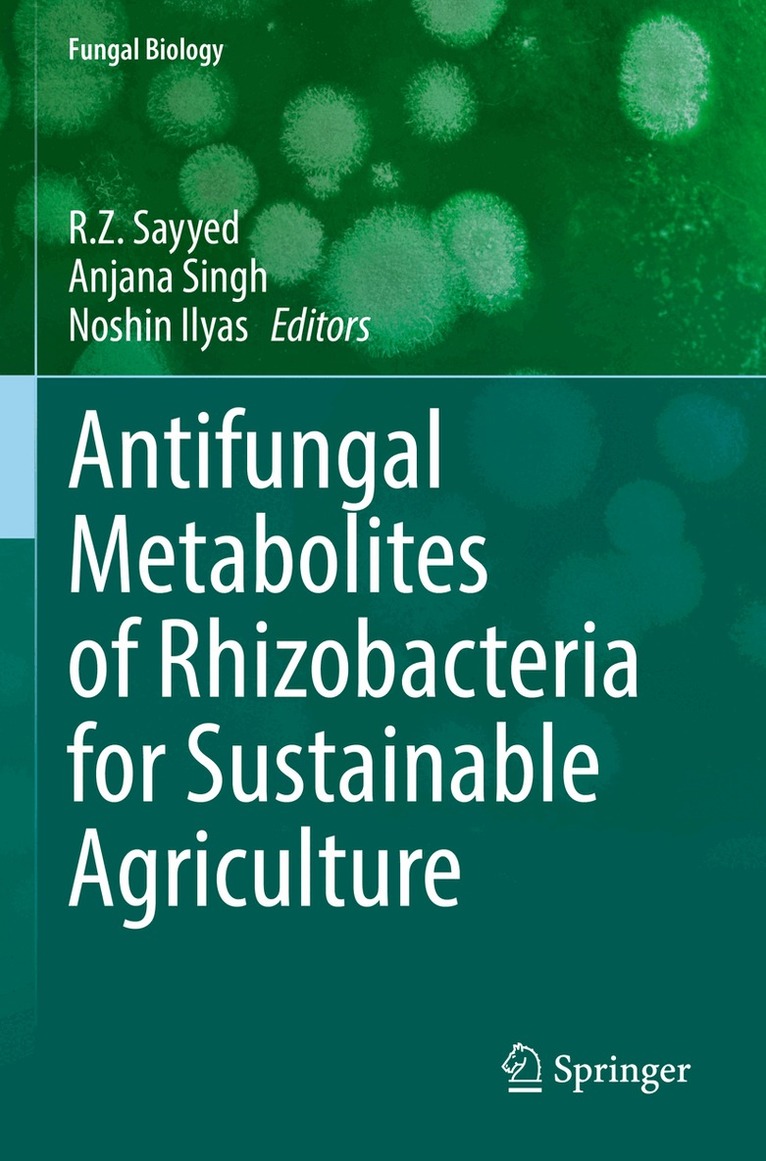

Anjana Singh – författare
1 633 kr
Skickas inom 10-15 vardagar
1 995 kr
Läs direkt efter köp
Antifungal Metabolites of Rhizobacteria for Sustainable Agriculture focuses on plant health in agro-ecosystems of various economically important cash and food crops with a concern to promote sustainable agriculture. They have emerged as a key organic tool for enhancing yields. In a natural environment the interactions between plants and phytopathogenic fungi are complex and survival requires a development of resistance to plant diseases. Diversity of Plant Growth Promoting Rhizobacteria (PGPR) diversity depends on the nature of root exudates and soil conditions that affect their interaction with host plants. Novel strategies, such as, applying bioactive natural products against the pathogenic fungus are required to control disease sustainably. Various classes of secondary metabolites including lipopeptides, macrolides, alkaloids, terpenoids and phenolics from microorganisms and plants strongly suppress fungal growth and can also be effective in controlling plant diseases both in vitro and in vivo. The modes of actions of some potential antifungal secondary metabolites against pathogenic fungus are also discussed.
Eco-friendly fungal species and their metabolites are excellent agents used for regulating various fungal and bacterial phytopathogens and may have tremendous potential for other applications, and play a key role in enhancing plant tolerance to stress.
Antifungal Metabolites of Rhizobacteria for Sustainable Agriculture also covers bovine-based formulations used for sustainable production and nutritional security through horticultural crops, thereby addressing the problems associated with malnutrition and under-nutrition encountered by small and marginal farmers, as well as by families facing resource constraints. These techniques can also improve breathable air, drinkable water, and consumable foods. This book addresses the need to mitigate the health problems of peoplevia organic crop production and to improve the socio-economic status of farmers (especially in developing countries), and to revitalize agricultural sustainability.
1 633 kr
Skickas inom 10-15 vardagar
Threads of Indigeneity in Central India
Essays on Adivasi History and Politics
1 793 kr
Skickas inom 10-15 vardagar
2 130 kr
Läs direkt efter köp
669 kr
Skickas inom 3-6 vardagar
Fort Cochin in Kerala, 1750-1830
The Social Condition of a Dutch Community in an Indian Milieu
1 859 kr
Skickas inom 5-8 vardagar
4 294 kr
Läs direkt efter köp
Women can be successful leaders if they achieve congruity between their inner instincts and their career goals. The World Woman today is at a threshold where she is confronting not only herself and her own inner feelings, historical conditioning and fears, but also managing interfaces in the outside world, both at home and workplace.This encyclopaedic study would be most useful for social scientists, teachers, parliamentarians, researchers and students in India and abroad.
4 294 kr
Läs direkt efter köp
Women can be successful leaders if they achieve congruity between their inner instincts and their career goals. The World Woman today is at a threshold where she is confronting not only herself and her own inner feelings, historical conditioning and fears, but also managing interfaces in the outside world, both at home and workplace.This encyclopaedic study would be most useful for social scientists, teachers, parliamentarians, researchers and students in India and abroad.
4 207 kr
Läs direkt efter köp
Women can be successful leaders if they achieve congruity between their inner instincts and their career goals. The World Woman today is at a threshold where she is confronting not only herself and her own inner feelings, historical conditioning and fears, but also managing interfaces in the outside world, both at home and workplace.This encyclopaedic study would be most useful for social scientists, teachers, parliamentarians, researchers and students in India and abroad.